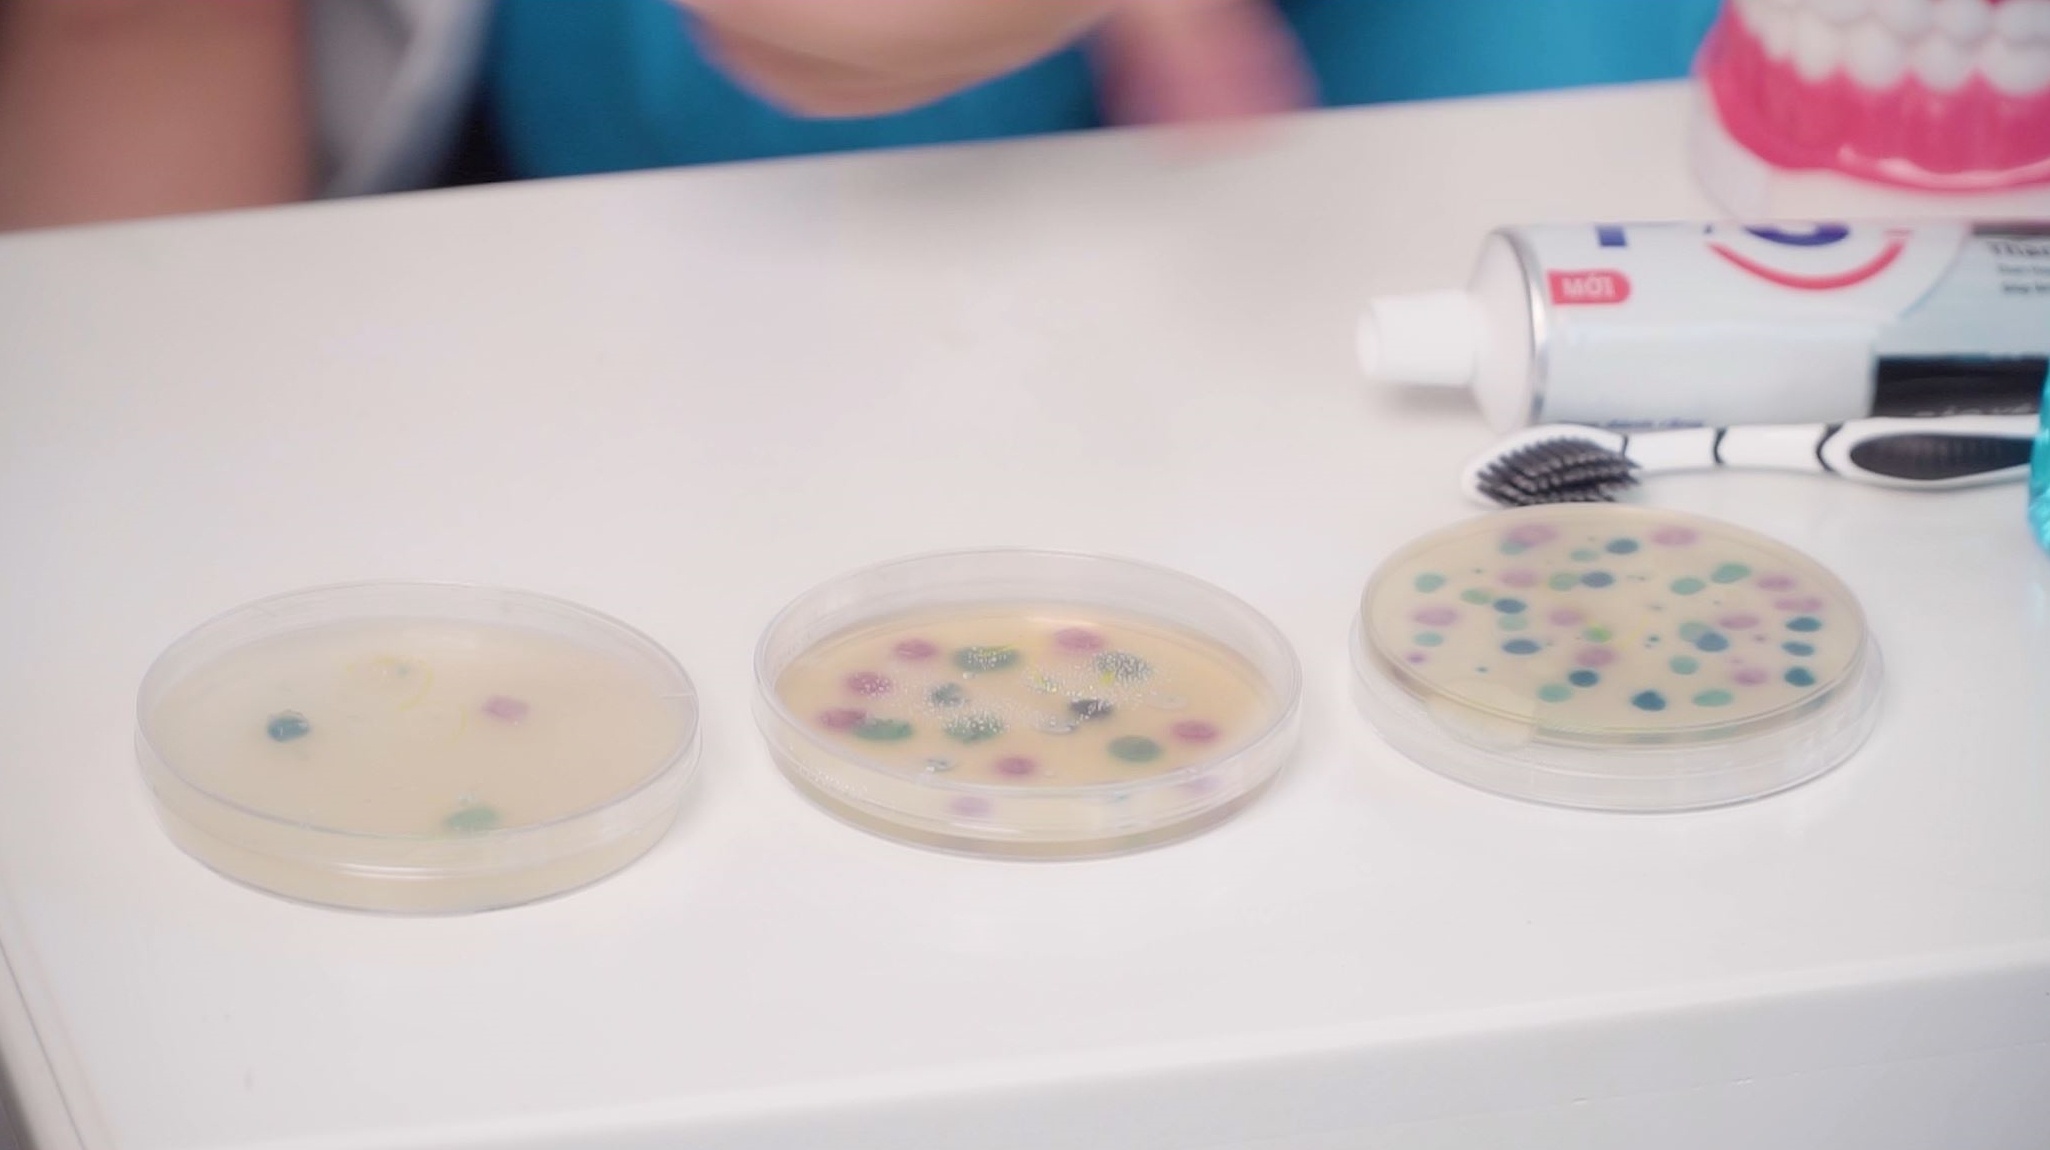
Bo 3 P/S khang khuan anh 1

Sau khi đại dịch Covid-19 xuất hiện, ai cũng thấy các thay đổi đáng kể trong lối sống, sinh hoạt thường ngày của chính mình và những người xung quanh. Không còn vô tư đến nơi đông người mà không có biện pháp bảo vệ, khẩu trang trở thành vật bất ly thân. Việc rửa tay bằng xà phòng được thực hiện thường xuyên hơn, gel rửa tay khô luôn sẵn sàng. Không những thế, nhà cửa, các bề mặt cũng được vệ sinh định kỳ, cẩn thận. Mọi người đều tự giác và quan tâm nhiều hơn đến việc chăm sóc sức khỏe.
Bên cạnh những biện pháp được nhắc đến mỗi ngày, BS. CK1. Hoàng Quốc Tưởng (Bệnh viện Nhi Đồng 2) còn chia sẻ thêm thói quen không mới nhưng chưa nhiều người thực hiện đúng và đủ. Đó là bảo vệ răng miệng - “cửa ngõ” quan trọng trong việc ngăn chặn virus, vi khuẩn tấn công cơ thể.
Trong một vlog của mình, bác sĩ cho biết khoang miệng là nơi sinh sống của hơn 700 loại vi khuẩn khác nhau. Vệ sinh răng miệng không đúng cách sẽ dẫn đến các bệnh lý nhiễm trùng răng miệng, tạo lỗ hổng để vi khuẩn xâm nhập vào cơ thể. Không chỉ Covid-19, nhiều virus và vi khuẩn gây bệnh khác như viêm họng, viêm mũi, viêm nướu, viêm hô hấp trên, viêm phổi… đều tấn công thông qua đường mũi họng, sau khi xâm nhập sẽ bắt đầu hoành hành và gây bệnh cho cơ thể.
“Vì thế, việc chăm sóc răng miệng đúng cách cũng như súc miệng với dung dịch kháng khuẩn thường xuyên, được xem là bước thiết lập và củng cố chốt chặn virus, vi khuẩn gây bệnh cuối cùng trước khi chúng tấn công sâu hơn vào cơ thể”, bác sĩ Tưởng chia sẻ.
Để bảo vệ răng miệng đúng cách và toàn diện, bác sĩ Hoàng Quốc Tưởng khuyên dùng bộ 3 bàn chải kháng khuẩn, kem đánh răng kháng khuẩn và nước súc miệng kháng khuẩn mỗi ngày. Súc miệng 2 lần mỗi ngày, mỗi lần 20 ml trong 30 giây sau khi đánh răng, thay bàn chải sau mỗi 3 tháng, bởi sau thời gian này trên bàn chải có tới 4 triệu vi khuẩn, là những lưu ý ai cũng cần biết.
Song song đó, bác sĩ Tưởng cũng thực hiện thí nghiệm nhỏ, chỉ ra sự khác biệt rõ rệt giữa việc đánh răng với nước, đánh răng cùng kem đánh răng và sử dụng thêm nước súc miệng kháng khuẩn sau khi đánh răng. Kết quả cho thấy, càng tăng cường kháng khuẩn (từ phải sang trái), tỷ lệ vi khuẩn càng giảm. Với mẫu có sử dụng nước súc miệng kháng khuẩn, tỷ lệ vi khuẩn giảm rõ rệt so với khi không sử dụng sản phẩm này.
|
| Kết quả thí nghiệm trích từ vlog của bác sĩ Hoàng Quốc Tưởng. |
Vlog hữu ích với phần thí nghiệm sinh động được cộng đồng mạng xem như bí kíp mới nhằm tăng cường bảo vệ sức khỏe mùa dịch. Nhiều mẹ cũng dùng vlog này để giáo dục nâng cao ý thức bảo vệ răng miệng tốt hơn cho con em. Đây là dấu hiệu khả quan cho thấy, việc phòng bệnh của cộng đồng sẽ hiệu quả hơn nếu mọi người biết nâng cấp thói quen chăm sóc răng miệng đúng và đủ.
Kết hợp cùng những thói quen sức khỏe khác, việc chăm sóc răng miệng với bộ 3 P/S kháng khuẩn, đặc biệt là nước súc miệng kháng khuẩn sẽ giúp cơ thể mạnh mẽ hơn trước các tác nhân gây bệnh, góp phần củng cố sức khỏe và phòng ngừa dịch bệnh hiệu quả.
 |
Bộ 3 P/S kháng khuẩn gồm nước súc miệng P/S với công thức Zinc Mineral, giúp kháng khuẩn 99,9% (**); kem đánh răng than hoạt tính và bàn chải than bạc có công dụng giúp cản phá 99,9% (*) vi khuẩn.
Sử dụng nước súc miệng kháng khuẩn sau khi đánh răng 2 lần/ngày là thói quen giúp củng cố “chốt chặn cuối cùng”, ngăn không cho vi khuẩn gây bệnh xâm nhập vào cơ thể, bảo vệ sức khỏe cho cả gia đình.
(*) - Dựa trên kết quả trong phòng thí nghiệm, trên các loại vi khuẩn E.coli, P.aeruginosa, S.typhi.
- Đối với bàn chải than bạc: Đề cập đến vi khuẩn trên lông bàn chải theo kết quả thí nghiệm.
(**) Trong điều kiện thí nghiệm trên các loại vi khuẩn có thể vào đường miệng: E.coli, P.aeruginosa, S.typhi, B.Subtilis, S.flexneri.



Bình luận